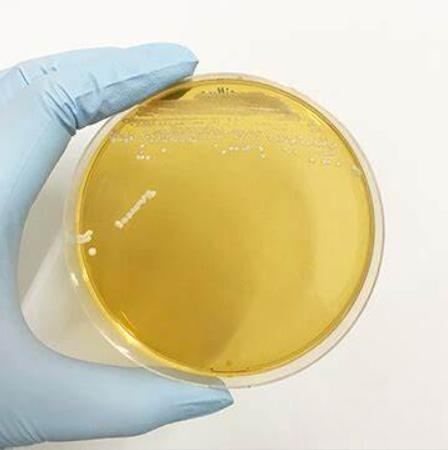

Кухонные ножницы. Каталог №1 (Biological Chemical Products)
Найдено товаров -

Пищевая добавка для ухода за здоровьем Insen
- Раздел: Biological Chemical Products
- Магазин: Hunan Insen Biotech Co., Ltd.

Порошок-пробиотик для лактобациллуса
- Раздел: Biological Chemical Products
- Магазин: Hunan Mol Changes Biotechnology Co., Ltd.

Высококачественный порошковый пробиотик Lactobacillus Sporogenes
- Раздел: Biological Chemical Products
- Магазин: Taian Biotechnology (shaanxi) Co., Ltd.


Бактерии пробиотиков Bacillus Subtilis для коров и домашней птицы
- Раздел: Biological Chemical Products
- Магазин: Shandong Sukahan Biotechnology Co., Ltd.



Пробиотики, объемная кормовая добавка, полезные бактерии для аквакультуры
- Раздел: Biological Chemical Products
- Магазин: Shandong Tianrunhe Bio-Engineering Co., Ltd.

Смесь пробиотиков ежедневно для детей, порошок бифидобактерий
- Раздел: Biological Chemical Products
- Магазин: Xian Gawen Biotechnology Co., Ltd.

Быстрая доставка протеазный порошок/кислотный протеазный фермент/кислотная протеаза
- Раздел: Biological Chemical Products
- Магазин: Weifang Joylong Bio-Technology Co., Ltd.

Пищевой пробиотический порошок Lactobacillus Plantarum оптом
- Раздел: Biological Chemical Products
- Магазин: Shaanxi Lifecare Biotechnology Co., Ltd.

Улучшенные микробы для очистки сточных вод/контейнер MBBR/ферменты и бактерии для очистки сточных вод
- Раздел: Biological Chemical Products
- Магазин: Weifang Yuexiang Chemical Co., Ltd.

Manufacturer producing mannanase enzyme for animal feed additive
- Раздел: Biological Chemical Products
- Магазин: Sunson Industry Group Co., Ltd.

Тесто Sunson, фермент, ксиланаза, пища для выпечки, улучшая обрабатываемость теста
- Раздел: Biological Chemical Products
- Магазин: Sunson Industry Group Co., Ltd.

Производитель, производящий фермент маннаназы для кормовой добавки для животных
- Раздел: Biological Chemical Products
- Магазин: Sunson Industry Group Co., Ltd.

Гарантированное качество, номер Cas 98-92-0, 3-пиридинкарбоксамид никотинамид, витамин B3
- Раздел: Biological Chemical Products
- Магазин: Shandong Yinglang Chemical Co., Ltd.

Таблетки пробиотиков Lactobacillus Acidophilus, частные марки
- Раздел: Biological Chemical Products
- Магазин: Huaqing (Xian) Natural Ingredients Co.,Ltd

Кухонные ножницы. Каталог №1
Кухонные ножницы – незаменимая вещь в любой кухне. Они помогают быстро и легко нарезать овощи, фрукты, зелень и мясо. Также ножницы можно использовать для открывания упаковок, обрезания верхушек яиц, резания рыбы и многих других задач, с которыми сталкивается каждый день в своей кухне.
Купить кухонные ножницы можно в нашем интернет-магазине. Мы предоставляем большой выбор ножниц различной формы и функциональности, которые станут незаменимыми помощниками на кухне.
Каждая хозяйка знает, что качественные кухонные ножницы – это гарантия удобной и быстрой работы. Не стоит экономить на качестве при выборе ножниц, так как они будут использоваться ежедневно. В нашем магазине вы найдете ножницы из высококачественной нержавеющей стали, с удобными ручками и лезвиями, способными продержаться долгое время.
Купить кухонные ножницы у нас – это не только выгодно, но и удобно. Вам не придется тратить время на походы по магазинам в поисках нужной модели ножниц, а также на оплату стоянок и бензина.
Заказы в нашем интернет-магазине обрабатываются максимально быстро и качественно. Вы получите товар в кратчайшие сроки, а также сможете воспользоваться нашими акциями и скидками.
Так что, если вы ищете качественные и удобные кухонные ножницы – купить их стоит у нас. Мы гарантируем качество товара и высочайший уровень обслуживания. Не откладывайте покупку на потом, сделайте заказ уже сегодня и выберите идеальную модель ножниц для своей кухни!